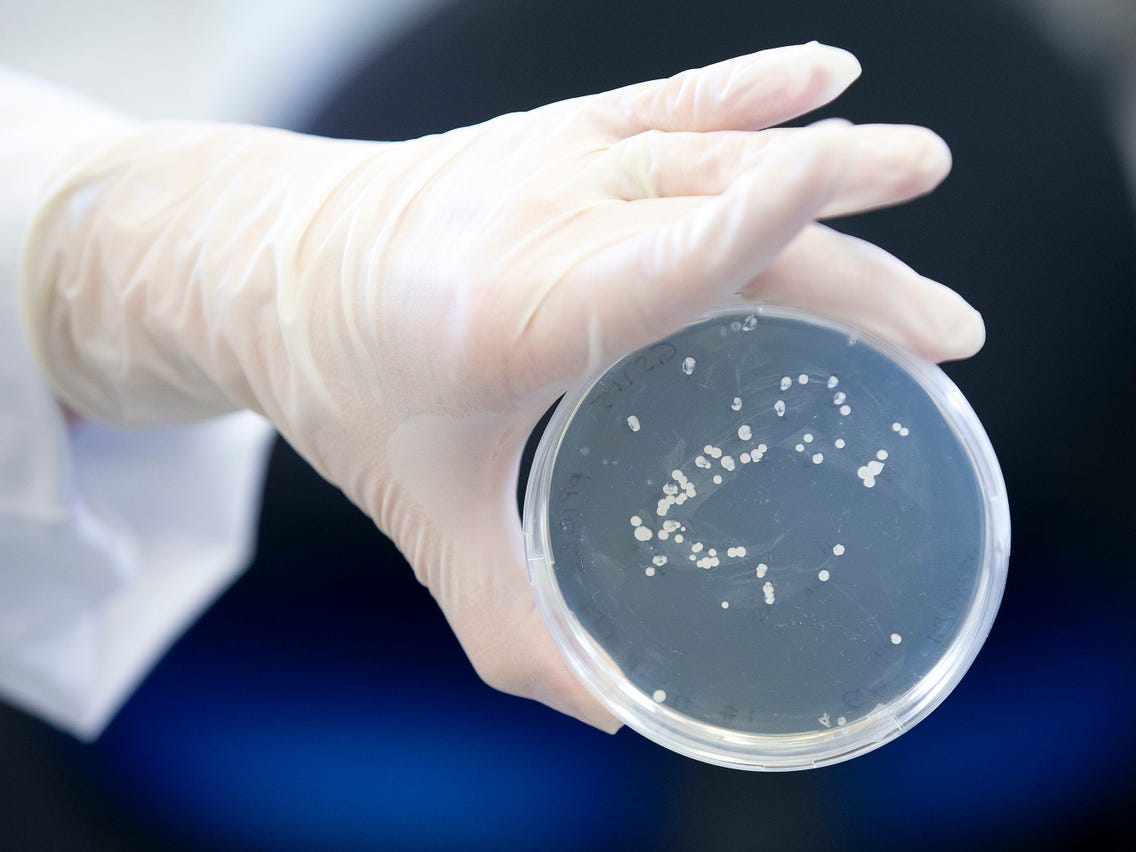
Khi giải tr&igrave;nh tự gene của virus, kết quả của người t&aacute;i nhiễm cho thấy 2 bộ gene virus ở 2 lần dương t&iacute;nh l&agrave; kh&aacute;c nhau.

Omicron và hiện tượng “xét nghiệm dương tính hơn một lần”
Khả năng miễn dịch có được sau khi mắc Covid-19 dường như kém hiệu quả hơn đối với biến thể Omicron dù nguy cơ bệnh chuyển biến nặng là thấp. Đây là cảnh báo đưa ra mới đây của giới khoa học trong bối cảnh số ca tái nhiễm gia tăng mạnh thời gian gần đây…

Tái nhiễm lần đầu tiên được đưa vào thống kê tổng quan chính thức về Covid-19 ở Anh, tính ngược trở lại thời điểm bắt đầu đại dịch. Cho đến nay, chỉ những trường hợp nhiễm lần đầu được ghi nhận, nhưng với những biến thể như Omicron tiếp tục xuất hiện, thì việc tái nhiễm sẽ trở nên phổ biến hơn. Từ đó, các quan chức y tế cũng sử dụng một định nghĩa nghiêm ngặt nhưng được khuyến nghị nên sử dụng phổ biến về tái nhiễm, để chỉ ra sự khác biệt giữa các trường hợp có hơn một lần xét nghiệm dương tính với virus SARS-CoV-2.
TÁI DƯƠNG TÍNH VÀ TÁI NHIỄM: LƯU Ý KHI XÉT NGHIỆM
Theo định nghĩa của WHO, tái nhiễm Covid-19 được định nghĩa là tình trạng một người đã bị nhiễm virus SARS-CoV-2, sau khi khỏi bệnh (âm tính hoàn toàn) lại nhiễm virus gây bệnh Covid-19 một lần nữa. Xét nghiệm RT-PCR thường cho kết quả CT thấp hơn 30 ít nhất 2 lần. Khi giải trình tự gene của virus, kết quả cho thấy 2 bộ gene virus ở 2 lần dương tính là khác nhau, bao gồm cả trường hợp giải mã gene ra 2 biến chủng khác nhau. Các xét nghiệm sâu hơn còn cho thấy, khi nuôi cấy, những virus này vẫn còn sống, vẫn đang hoạt động và có thể nhân lên.
Nguyên nhân của trường hợp này là do sau khi khỏi bệnh hoặc sau khi tiêm đủ 2 mũi vaccine phòng ngừa Covid-19, mặc dù cơ thể đã tạo kháng thể chống lại virus gây bệnh, nhưng số lượng kháng thể ở mỗi người là khác nhau. Những người có ít kháng thể, kháng thể không đủ mạnh, bị bệnh nền, cơ địa kém, lại không tuân thủ nghiêm ngặt 5K, thì khi tiếp xúc với F0 do biến chủng mới gây ra, sẽ có nguy cơ cao bị tái nhiễm.
Trong khi đó, tái dương tính Covid-19 là tình trạng người bệnh có kết quả xét nghiệm Covid-19 âm tính – dương tính lẫn lộn nhiều lần trong vòng 90 ngày kể từ lần bị bệnh đầu tiên. Cụ thể hơn, tái dương tính là khi một người bị nhiễm virus SARS-CoV-2, sau quá trình điều trị, test nhanh cho ra kết quả âm tính, nhưng sau vài tuần lại có kết quả xét nghiệm RT-PCR dương tính (thường CT trên 30) dù không có bất kỳ triệu chứng nào của bệnh.
Nguyên nhân của hiện tượng này được cho là do độ nhạy của xét nghiệm RT-PCR rất cao. Đồng thời, vì virus có thể tồn tại trong cơ thể từ vài tuần cho đến vài tháng sau khi khỏi bệnh, nên xét nghiệm này cho ra kết quả dương tính. Tuy nhiên, khi giải trình tự gene virus SARS-CoV-2 của 2 lần dương tính thì cho ra kết quả 2 bộ gene virus giống nhau. Khi đem nuôi cấy, những virus này không còn hoạt động, không có sự nhân lên. Các nhà nghiên cứu khẳng định đây chỉ là các mảnh xác virus còn sót lại.
OMICRON LÀM GIA TĂNG TỶ LỆ TÁI NHIỄM?
Mặc dù tỷ lệ tái nhiễm thấp hơn so với tỷ lệ tái dương tính, sự xuất hiện của các chủng mới có nguy cơ lây nhiễm nhanh khiến tỷ lệ tái nhiễm tăng lên trong thời gian gần đây. Tại New York, Hoa Kỳ, tính đến giữa tháng 2/2022 đã có khoảng 200.000 trường hợp tái nhiễm, chiếm khoảng 4% tổng số ca bị Covid-19.
Tương tự tại Anh, hơn 650.000 người tại nước này được cho là có thể đã mắc Covid-19 tới 2 lần và phần lớn xảy ra kể từ khi biến thể Omicron được phát hiện. Theo Cơ quan An ninh Y tế Anh, một người bị coi là tái nhiễm nếu như lần mắc sau cách lần mắc trước đó ít nhất 3 tháng. Cho đến giữa tháng 11 năm ngoái, tỷ lệ tái nhiễm chỉ chiếm khoảng 1% trong tổng số các ca mắc, nhưng tỷ lệ này hiện nay là 10%.
Một nghiên cứu khác được tiến hành tại Qatar và được đăng trên Tạp chí Y học New England hồi tháng này cho thấy, mặc dù miễn dịch tạo ra từ lần nhiễm bệnh trước đó có hiệu quả ngăn ngừa tới 90% đối với các biến thể Alpha, Beta hay Delta, nhưng với Omicron chỉ khoảng 56%. "Tình hình hiện nay thực sự khác biệt. Chúng ta đang nói về một loại biến thể với nhiều đặc tính tấn công hệ miễn dịch hơn", Laith Abu-Raddad, chuyên gia dịch tễ học bệnh truyền nhiễm tại trung tâm y khoa Weill Cornell Medicine-Qatar ở Doha nói.
Những nghiên cứu đã chỉ ra rằng, Omicron có thể vượt qua hàng rào miễn dịch tạo ra bởi vaccine. Giờ đây, Abu-Raddad và các chuyên gia khác đang nghiên cứu xem Omicron có thể tấn công các kháng thể sản sinh từ các lần nhiễm virus SARS-CoV-2 trước đó như thế nào. "Xác định tỷ lệ tái nhiễm là điều quan trọng nhằm đánh giá làn sóng lây nhiễm và tiên lượng trước khả năng ứng phó của các bệnh viện," Catherine Bennett- nhà dịch tễ học tại ĐH Deakin ở Melbourne, Australia cho biết.

Theo tờ The Times of India, nhiều dữ liệu nghiên cứu vào năm 2021 cho biết với những người hồi phục sau Covid-19, khả năng miễn dịch của họ có thể kéo dài khoảng 3 tháng đến 1 năm. Tuy nhiên, tiến sĩ S.N Aravinda, chuyên gia tư vấn - nội khoa, Bệnh viện Aster RV Bangalore (Ấn Độ), lưu ý khả năng miễn dịch có thể đã rút ngắn xuống còn 4 - 8 tuần trong thời gian gần đây.
Ông Aravinda cũng nhận định, lý do chính đằng sau việc giảm khả năng miễn dịch là sự xuất hiện của các biến thể Covid-19 khác nhau. Cơ thể liên tục phát triển và thích nghi với môi trường. Khi một người được tiêm vaccine, cơ thể sẽ ghi nhớ mô hình hành vi của virus loại đó và chuẩn bị sẵn sàng để chống lại nó, đây được gọi là trí nhớ miễn dịch. Theo thời gian, trí nhớ này sẽ dần suy giảm.
Trước những thông tin này, WHO đã lên tiếng cảnh báo những người từng mắc Covid-19 vẫn có thể tái nhiễm với biến chủng Omicron và nguy cơ này đang gia tăng trên toàn cầu. Tổng giám đốc Tổ chức Y tế thế giới Tedros Adhanom Ghebreyesus cho rằng, virus vẫn đang lưu hành mạnh và nhiều người vẫn dễ bị tổn thương. Vì thể việc tuân thủ các quy định về phòng chống dịch vẫn rất quan trọng.
“Tôi kêu gọi mọi người cố gắng hết sức để giảm nguy cơ lây nhiễm để giúp giảm bớt áp lực cho hệ thống y tế. Bây giờ không phải là lúc để từ bỏ và vẫy cờ trắng. Chúng ta vẫn có thể giảm thiểu đáng kể tác động của làn sóng tái nhiễm hiện tại bằng cách chia sẻ và sử dụng hiệu quả các công cụ y tế cũng như thực hiện các biện pháp xã hội và sức khỏe cộng đồng đã được chứng minh hiệu quả,” Ông Tedros nói.

TP.Hồ Chí Minh ban hành Quy chế xét chọn danh hiệu doanh nghiệp, doanh nhân TP.Hồ Chí Minh tiêu biểu

Nhà nước hỗ trợ tới 100% lãi vay cho doanh nghiệp công nghệ chiến lược

Bão số 1 suy yếu nhưng mưa lũ còn phức tạp, Quảng Ninh thiệt hại bước đầu

Quảng Ngãi sẽ đầu tư 6.000 tỷ đồng triển khai dự án đường ven biển Dung Quất - Sa Huỳnh, tạo đột phá cho phát triển kinh tế và du lịch
DANAFF IV: Cầu nối điện ảnh Châu Á và thế giới
Với chủ đề “Nhịp cầu từ Châu Á ra thế giới - Bridging Asia to the World”, Liên hoan phim Châu Á Đà Nẵng lần thứ IV (DANAFF IV) đã chính thức khép lại sau một tuần lễ điện ảnh quốc tế sôi động tại thành phố biển xinh đẹp bằng Lễ Bế mạc và trao giải…
Đà Nẵng thúc đẩy chuyển đổi số trong thương mại
Tối 3/7, tại Quảng trường Sông Hoài, Hội An, Sở Công Thương thành phố Đà Nẵng phối hợp với Cục Thương mại điện tử và kinh tế số, Bộ Công Thương, tổ chức khai mạc Phiên chợ thương mại điện tử kết nối sản phẩm truyền thống vùng miền Đà Nẵng 2026...
Đám cưới của Taylor Swift có chi phí lên đến hàng chục triệu USD vì lý do an ninh
Ca sĩ Taylor Swift và vận động viên bóng bầu dục Travis Kelce dự kiến tổ chức lễ cưới vào cuối tuần này tại Madison Square Garden, New York. Và ngay cả với một cặp đôi tỷ phú, con số chi phí ước tính vẫn khiến người ta phải giật mình.
Những chiến lược truyền thông “ăn theo” các ngôi sao World Cup
Không chỉ là ngày hội bóng đá lớn nhất hành tinh, World Cup 2026 được kỳ vọng tạo ra hiệu ứng lan tỏa mạnh mẽ đến du lịch, thương mại và đầu tư. Sức hút của giải đấu cũng giúp gia tăng giá trị thương mại cho các đơn vị sở hữu bản quyền cũng như các thương hiệu tài trợ…
Công nghệ AI mở ra phân khúc mới trên thị trường thiết bị dành cho vật nuôi
Làn sóng ứng dụng trí tuệ nhân tạo (AI) đang mở ra một phân khúc mới trên thị trường thiết bị gia dụng dành cho vật nuôi. Đối với thế hệ Gen Z, việc nuôi thú cưng gắn liền với các giải pháp tiện lợi và đây chính là điểm chạm để công nghệ thâm nhập thị trường...
Nhìn lại di sản và thành tựu của Thời báo Kinh tế Việt Nam (nay là Tạp chí Kinh tế Việt Nam) trong 35 năm qua, giá trị lớn nhất không chỉ đo bằng lượng thông tin phục vụ bạn đọc hàng ngày, hàng giờ, cũng không chỉ ở tên gọi và số lượng các ấn phấm báo chí đã phát hành, mà còn được thể hiện ở tư duy bứt phá của những thế hệ lãnh đạo được giao nhiệm vụ thực hiện sứ mệnh phát triển “dòng thông tin kinh tế phục vụ công cuộc kiến tạo và phát triển đất nước”.
 25/34 địa phương có mức tăng trưởng thấp hơn mục tiêu
25/34 địa phương có mức tăng trưởng thấp hơn mục tiêu
Tăng trưởng kinh tế 8,18%, chưa đạt mục tiêu đề ra là 9,7%. Có 25/34 địa phương tăng trưởng thấp hơn mục tiêu. Cơ cấu thương mại còn nhiều rủi ro. Xuất khẩu tăng cao nhưng nhập khẩu tăng nhanh hơn… Đó là những thách thức được Bộ trưởng, Chủ nhiệm Văn phòng Chính phủ Đặng Xuân Phong đề cập tại Họp báo Chính phủ thường kỳ vừa diễn ra tại Hà Nội.
























